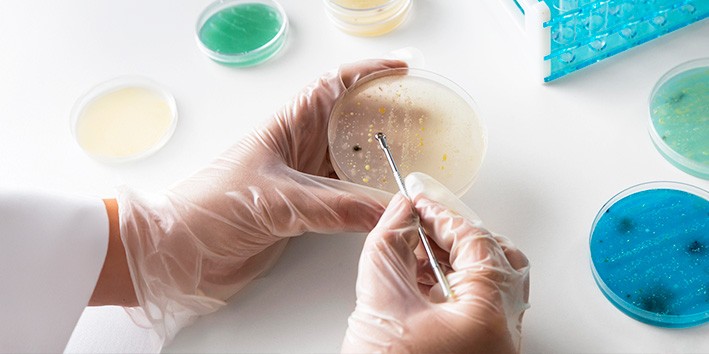
Agar-agar o que e gelatina

Para que serve Ágar-ágar? Entenda os benefícios!
Conheça nossas fórmulas magistrais para Agar-Agar.
Veja nossa lista de opções:
90 cápsulas de 400mg,
Índice do conteúdo
O Ágar-ágar já é bem conhecido na alimentação, fazendo parte até da confeitaria. Mas há benefícios para nossa saúde que nem todos sabem — inclusive, pode auxiliar em regimes de emagrecimento. Entenda melhor o uso medicinal do Ágar-ágar neste artigo!

O que é Ágar-ágar?
O Ágar-ágar é um ingrediente bem conhecido na cozinha, ainda mais na confeitaria vegana — afinal, ajuda muito bem a preparar receitas que necessitam de consistências gelatinosas para pessoas que não comem alimentos de origem animal. Quando não se trata de uma gelatina em si, ajuda também para espessar cremes, conservas de frutas e até mesmo sopas.
E se você não sabe da origem do Ágar-ágar, saiba que é um material extraído de algas marinhas vermelhas. Não há uma única espécie que oferece o Ágar, mas tais algas são da classe Rhodophyta, cujos principais gêneros botânicos envolvidos são Gelidium, Gracilaria, Gelidiela e Pterocladia.
E por que "Ágar-ágar"?
O termo vem do malaio, um dos idiomas da Malásia — mas que não se limita somente a esse país, pertencendo à toda austronésia. Esse termo se referia às algas vermelhas do gênero Gelidium. Já nas Filipinas, o Ágar-ágar é conhecido como "gulaman" na língua tagalo, sendo usado como alimento ou ingrediente pelas populações nativas de lá. Há outros tipos de rodófitas utilizadas pelos povos originários da região, como o gusô, nas Filipinas, cujo registro de uso data 1637.
Mas foi no Japão, onde o Ágar-ágar é chamado lá de "kanten", que essas microalgas tiveram maior destaque devido a descobertas sobre a extração de agarose. Os primeiros registros vêm a partir de 1650 no Japão, uma descoberta geralmente atribuída a Mino Tarōzaemon. A história popular conta que ele deixou um prato de sopa de algas ao ar livre e, quando voltou, notou a solidificação da sopa — que se tornou gelatina. Reidratar deixou-a ainda mais gostosa. E dali para frente, mais experimentações com algas e suas propriedades de gelificação foram feitas!
Inclusive, Ágar-ágar é importante também para a história da microbiologia, pois é atóxico e ideal para cultivo de microrganismos em Placas de Petri, para posteriores estudos.
Hoje, podemos aproveitar o Ágar-ágar de diferentes formas, mesmo estando tão distantes do Sudeste e Leste Asiáticos. Agora que você sabe um pouco mais sobre a fascinante história do Ágar-ágar, é hora de entender a ação dele na saúde!
Ágar-ágar: para que serve
De modo geral, o Ágar-ágar é indicado como fitoterápico adjuvante para metas de emagrecimento. Sendo rico em fibras, também auxilia na constipação, no controle de colesterol e no controle de índices glicêmicos.
Para fins medicinais, utiliza-se o Ágar-ágar em pó. Em geral, seus componentes são:
- Fibras
- Sais minerais (P, Fe, K, Cl, I)
- Celulose
- Proteínas (em pequenas quantidades)
- Agarose (galactose + anidrogalactose) e Agaropectina
O Ágar-ágar é usado em dietas de emagrecimento, agindo principalmente como:
- Laxante suave
- Indutor de saciedade
Ele é vendido na forma de cápsulas aqui na Oficina de Ervas, embora você encontre outras formas para uso culinário.

E quais são as indicações de uso do Ágar ágar?
Pela presença de fibras, não se trata apenas de uma opção para constipações ou dietas de emagrecimento! Vamos conferir todas as indicações de uso medicinal do Ágar-ágar:
- Auxílio na perda ou manutenção de peso
- Controle de colesterol
- Controle sensível de índices glicêmicos
- Combate à constipação (prisão de ventre)
- Auxílio aos cuidados do coração (justamente pelo impacto no colesterol e pela melhora sensível da diabetes, que é um fator de risco para problemas no coração)
Fibras alimentares são muito benéficas à nossa saúde! O Ágar-ágar é uma fibra solúvel que se expande dentro do nosso corpo. Forma um tipo de gel no estômago. É por isso que ele tem essa fama de reduzir o apetite, pois provoca essa sensação de saciedade. E por ter também um baixíssimo valor calórico, é um aliado poderoso para metas de emagrecimento ou manutenção de peso.
E é claro, sendo uma fibra, também melhora o trânsito intestinal. Tem também ação laxativa suave, facilitando a evacuação. Só precisamos tomar cuidado para não ingerir fibras demais, incluindo Ágar-ágar, sem uma excelente quantidade de água. Ao consumir Ágar-ágar ou outras fibras, precisamos ficar de olho na hidratação para não causar a temida prisão de ventre. Afinal, as fezes precisam de água para ficarem na consistência correta de uma evacuação fácil, regular e sem dores.
Para descobrir a quantidade ideal de água que você deve ingerir por dia, basta multiplicar 35mL pelo peso do seu corpo. Por exemplo: uma pessoa que pesa 60 quilos (35mL x 60kg = 2100mL) deve ingerir 2,1 litros de água por dia. Então, se você começar a usar o Ágar-ágar, precisaria ingerir um pouco mais de água do que o ideal pelo seu peso.

Os impactos do Ágar-ágar sobre o colesterol e a glicemia também estão relacionados à rica presença de fibras. No caso do colesterol, as fibras solúveis se ligam aos ácidos biliares.
Para relembrar brevemente, o nosso colesterol serve para a produção desses ácidos biliares que atuam na digestão de gorduras.
Quando as fibras solúveis se ligam aos ácidos biliares, eles são secretados pelas fezes. Daí, o corpo tem a necessidade de produzir mais ácidos biliares! Então o fígado queima mais colesterol para produzir novos ácidos biliares. Assim, ao final do processo, há redução do colesterol circulante no sangue, já que ele foi usado como combustível para produção de ácidos biliares.
O efeito do Ágar-ágar sobre os índices glicêmicos é causado pela redução de absorção de glicose nos intestinos; pois retarda a absorção dos carboidratos. O maior controle sobre índices glicêmicos possivelmente está relacionada também com o efeito de saciedade, já que pacientes diabéticos também podem ter vontade de comer mais do que o ideal nas refeições. Com o Ágar-ágar, essa vontade é amenizada.
Dosagem usual recomendada
A dosagem depende da sua necessidade! Afinal, o Ágar-ágar pode ser usado para mais de uma finalidade, como metas de emagrecimento ou melhora de trânsito intestinal. Converse com nossos fitoterapeutas sobre seu caso e não deixe a sua saúde de lado! Entre em contato com um de nossos fitoterapeutas clicando aqui.
Atenção: O Ágar-ágar deve ser utilizado sempre com bastante água, pois é a água que vai fazer as fibras funcionarem. Se não houver uma boa ingestão de água diária, o Ágar-ágar pode piorar a prisão de ventre.
A dosagem usual por adultos é de 400mg à 1g, 2 vezes ao dia, antes das refeições e preferencialmente junto com 2 copos de água.
Ágar-ágar tem colágeno?
Apesar de ser um substituto da gelatina de origem animal em diversas receitas, o Ágar-ágar não tem colágeno — que é justamente um tipo de proteína animal. Mas o Ágar-ágar tem outras proteínas benéficas à saúde, que serão quebradas em aminoácidos pelo organismo e podem auxiliar o seu corpo na produção endógena de colágeno.
Afinal, seu corpo já produz colágeno. É só a quantidade que muda com o tempo. Para produzir bem, seu corpo precisa de nutriente suficiente e isso pode ser resolvido tanto com uma boa alimentação quanto com uma suplementação quando necessário.
Caso o seu interesse também seja para vitalidade da pele e cabelos e enrijecimento de outros tecidos, como unhas, você pode associar o uso do Ágar-ágar com Exsynutriment e Bioarct.

Ágar-ágar emagrece?
A capacidade do Ágar-ágar de aumentar a sensação de saciedade pode auxiliar sim nos regimes de emagrecimento. Mas não se esqueça: o tratamento para obesidade envolve uma série de medidas: atividade física, alimentação equilibrada com déficit calórico, acompanhamento psicológico e um possível auxílio farmacológico.
O auxílio farmacológico — ou seja, o uso de medicamentos, sejam naturais ou não — é um ponto bem sensível e que, assim como o restante de medidas adotadas, deverá respeitar as necessidades e características de cada paciente.
Se você sente muita fome e ansiedade, o ideal é se consultar com profissionais da área da Psicologia e Nutrição. O emagrecimento é uma jornada de muitas ações e atendimento médico multidisciplinar. Antes de comparar o seu corpo ao "antes e depois" de pessoas que alegam usar diversos produtos naturais para emagrecer (geralmente muito em pouco tempo), lembre-se que cada um tem um ritmo — e muita coisa que a gente vê na internet não é tão verdade assim.
Confira nossas 7 Dicas de emagrecimento saudável com plantas!
E para não cair ciladas, há nosso outro informativo que você pode ler clicando aqui: "Emagrecer rápido e fácil é possível? Cuidado com as Fake News!".

Ágar-ágar: efeitos colaterais e contraindicações
O Ágar-ágar não apresenta toxicidade e seu consumo é considerado seguro. Efeitos colaterais, quando ocorrem, variam entre dores abdominais, obstruções, gases e diarreia. Existem outros pontos importantes a serem considerados no consumo deste fitoterápico:
- Não recomenda-se o Ágar-ágar a gestantes ou lactantes sem orientação médica. Independente da fase da gravidez, busque profissionais da saúde antes de consumir fitoterápicos.
- Não é recomendado para crianças menores de 12 anos.
- Não é recomendado para pacientes hipersensíveis ou alérgicos aos seus componentes.
- Não é recomendado para pacientes com histórico de obstrução intestinal.
- Durante o tratamento com Ágar-ágar, recomenda-se aumentar a ingestão de líquidos porque a ação laxante acontece através da absorção de água no intestino. Beba bastante água!
- Existem indícios que a absorção de medicamentos pelo organismo é desacelerada. Caso esteja tomando outros remédios, consuma-os de 30min a 2h antes ou depois de tomar o Ágar-ágar. Se o medicamento é de uso contínuo, busque orientação médica.
Ágar-ágar: preço e onde comprar
Você pode comprar Ágar-ágar no nosso site, clicando aqui.
Em caso de dúvidas, você pode falar com nossos fitoterapeutas, clicando aqui.

Referências
https://www.webmd.com/beauty/vegan-collagen-what-to-know
https://pt.wikipedia.org/wiki/Ágar-ágar
https://blog.mundoverde.com.br/treino-e-suplementacao/existe-colageno-vegano/
https://www.asianscientist.com/2016/01/columns/history-agar-microbiology-lab/

Comentários
Vamos lá, seja o primeiro a comentar sobre: Para que serve Ágar-ágar? Entenda os benefícios!
Deixe seu comentário sobre:
Para que serve Ágar-ágar? Entenda os benefícios!